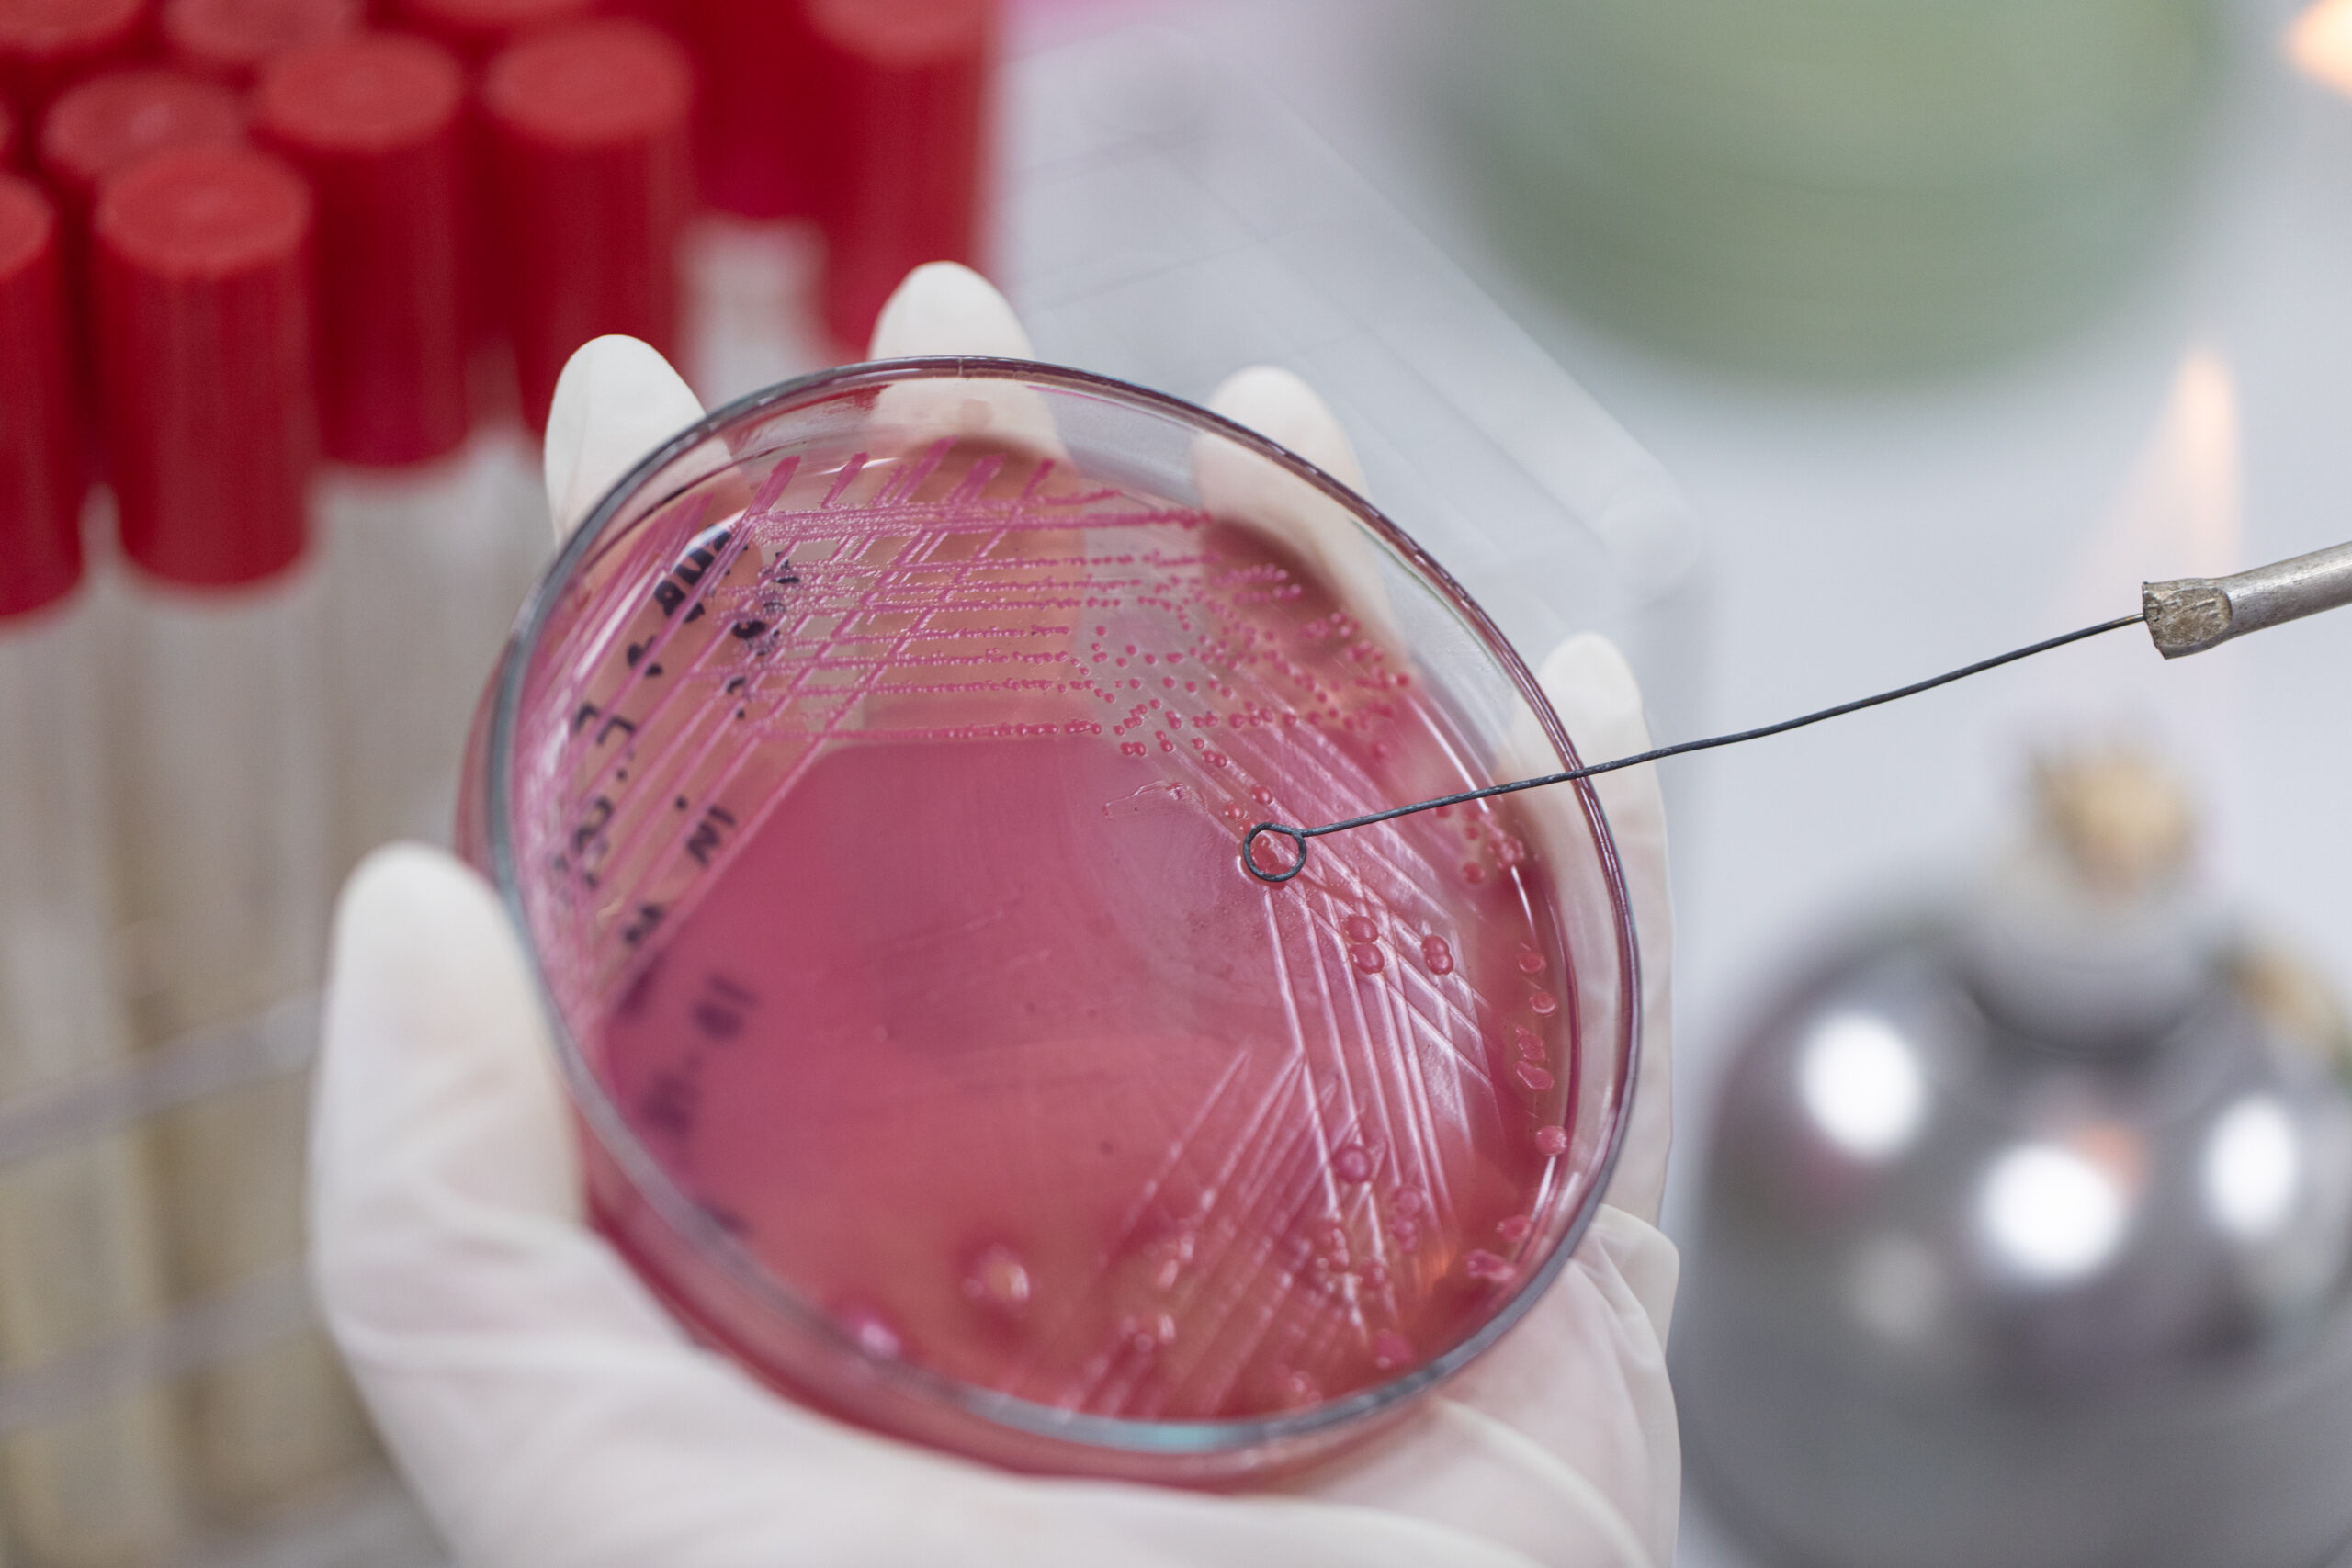
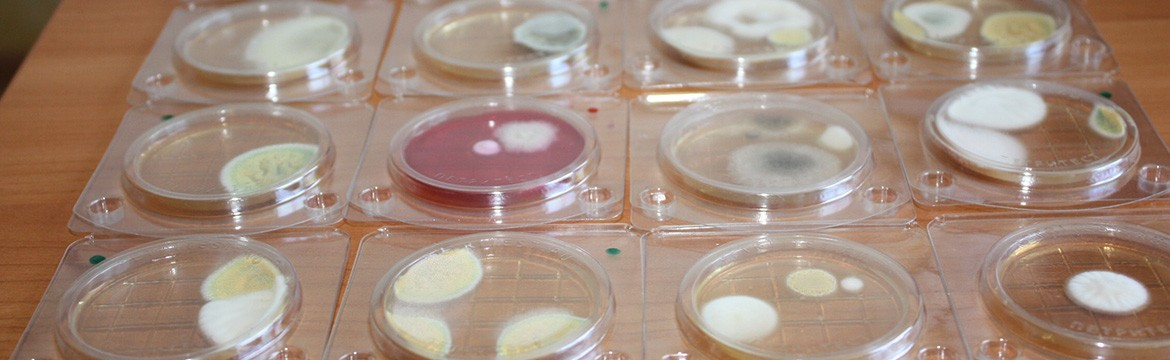

Исследование на бгкп
Common chest
Коврики карок
Оригинальное поздравление классного руководителя на выпускном вечере
Трансляция молодая пара
Задания на рациональные дроби 8 класс
Упаду поднимусь закричу
Модель плюс сайз вес
Экологичная среда это
Краткий пересказ строение вещества физика
Ближайшие события в москве
Ходатайство в судебном процессе
Мавуика внешность
Завивка волос видео
Исследование на бгкп 109 фото